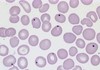

L5: Haemapoeisis Flashcards
(54 cards)
Define haemopoiesis
Production of blood cells (RBCs, platelets & most WBCs) which occurs in bone marrow
For both children & adults, state where bone marrow is commonly found and hence where haemopoiesis takes place
- Children: bone marrow extensive throughout skeleton
- Adults: pelvis, sternum, skull, ribs & vertebrate
Haemopoietic stem cells (hemocytoblasts) can mobilise out of bone marrow into peripheral blood
Where does haemopoiesis occur in the early embryo?
Yolk sac and then in the embryonic liver (at 5-8 weeks gestation)
State where you would obtain a bone marrow sample from
Right posterior iliac crest
State the name for the multipotent heamopoietic stem cell
Hemocytoblast
State three ways we can obtain haemopoietic stem cells
- Aspiration of bone marrow (RARE)
- GCSF mobilised stem cells in the peripheral blood (collected by leucopharesis)
- Umbilical cord (at time of normal delivery)
Describe the role of the RES (reticuloendothelial system)
Part of immune system which removes dead or damage cells and identifies and destroys foregin antigens in blood & tissue.
State the phagocytic cells of RES in:
- Blood
- Tissue (generic)
- Liver
- Connective tissue
- CNS
- Blood= monocytes (differentiate into macrophages when in tissue)
- Tissue (generic) = macrophages
- Liver = kupffer cells (macrophages in liver)
- Connective tissue = hitiocytes (macrophages can therefore be histiocytes)
- CNS: microglial cells
State the two maini organs of the RES
- Spleen
- Liver
Describe the role of the red pulp of the spleen in the RES
All blood passes through spleen where RES cells dispose of damaged or old cells (in particular RBCs). Hb is removed from RBCs and:
- Globin: degraded into amino acids
- Haem: metabolised into bilirubin which is then conjugated in liver and removed in bile
Where is the spleen located?
Left uppper quadrant of abdomen, just beneath diaphragm & posterior to stomach
Describe the role of the white pulp & the red pulp in the spleen
White pulp:
- Synthesises antiboides
- Removes anti-body coated bacteria
Red pulp:
- Remvoes old cells
- Metabolises haemoglobin

Describe structure of red pulp & white pulp of spleen.
- Red: sinuses lined with endothealil macrophages & cords
- White: simialr to lymphoid follicles
How does blood enter the spleen?
Splenic artery
State the four main functions of the spleen
- Sequestration & phagocytosis (blood filter)
- Blood pooling (platelets & RBCs can be rapidly mobilised during bleeding)
- Extramedullary haemopoiesis: pluripotent stem cells proliferate during haematological stress or if marrow fails
- Immunological function (contains B & T cells. Important in removing encapsulated bacteria)
What passes through red & white pulp of spleen?
- Red: RBC
- White: WBC & plasma
Define splenomegaly and sate some common causes:
Splenomegaly= enlargement of the spleen (NEVER NORMAL)
Causes:
- Back pressure (in liver disease, liver becomes fibrotic so hard to allow blood to flow through vessels in liver. Leads to increased pressure in vessels and increased pressure in spleen “portal hypertension”)
- Overworking red or white pulp
- Extramedullary haemopoiesis
- Presence of abnormal cells
- Contains other material that shoudln’t be there (e.g. in sarcoidosis you have increased gramulomas in spleen)
What advice should be given to patients with splenomegaly (particularly those who are active) and why?
Avoid dangerous activities which may involve trauma to spleen as since it is enlarged it is no longer protected by ribcage. Trauma to spleen could cause rupture leading to internal haemorrhage/haematoma.
Describe how you would examine the spleen for splenomegaly
Palpate below costal margin starting in the right iliac fossa. Should feel splen edge move towards you on inspiration. Measure, in cm, from costal margin to mid clavicular line.
Give two example conditions for if splenomegaly is:
- Massive
- Moderate
- Mild
- Massive: malaria, chronic myeloid leukaemia
- Moderate: infections (e.g. malaria) & liver cirrhosis
- Mild: endocardititis & infectious hepatitis
Define hyposplenism and state what is it associated with
Hyposplenism= reduced function of spleen
Associated with increased risk of sepsis
Describe what would be seen on a blood film of someone with hyposplenism and why
Howell-Jolly bodies (nuclear fragments/clusters of DNA) in circulating erythrocytes. During erythropoiesis, erythroblasts usually expel nuclei but sometimes this fails; normall, such cells would be removed by spleen but they are not due to reduced function of spleen (hyposplenism).
State two possible consequences of splenomegaly
- Rupture leading to haematoma
- Infarction of spleen due to compression of blood vessels as it enlarges
State two causes of hyposplenism
- Splenectomy
- Diseases that destroy spleen (e.g. sickle cell or coeliac)


